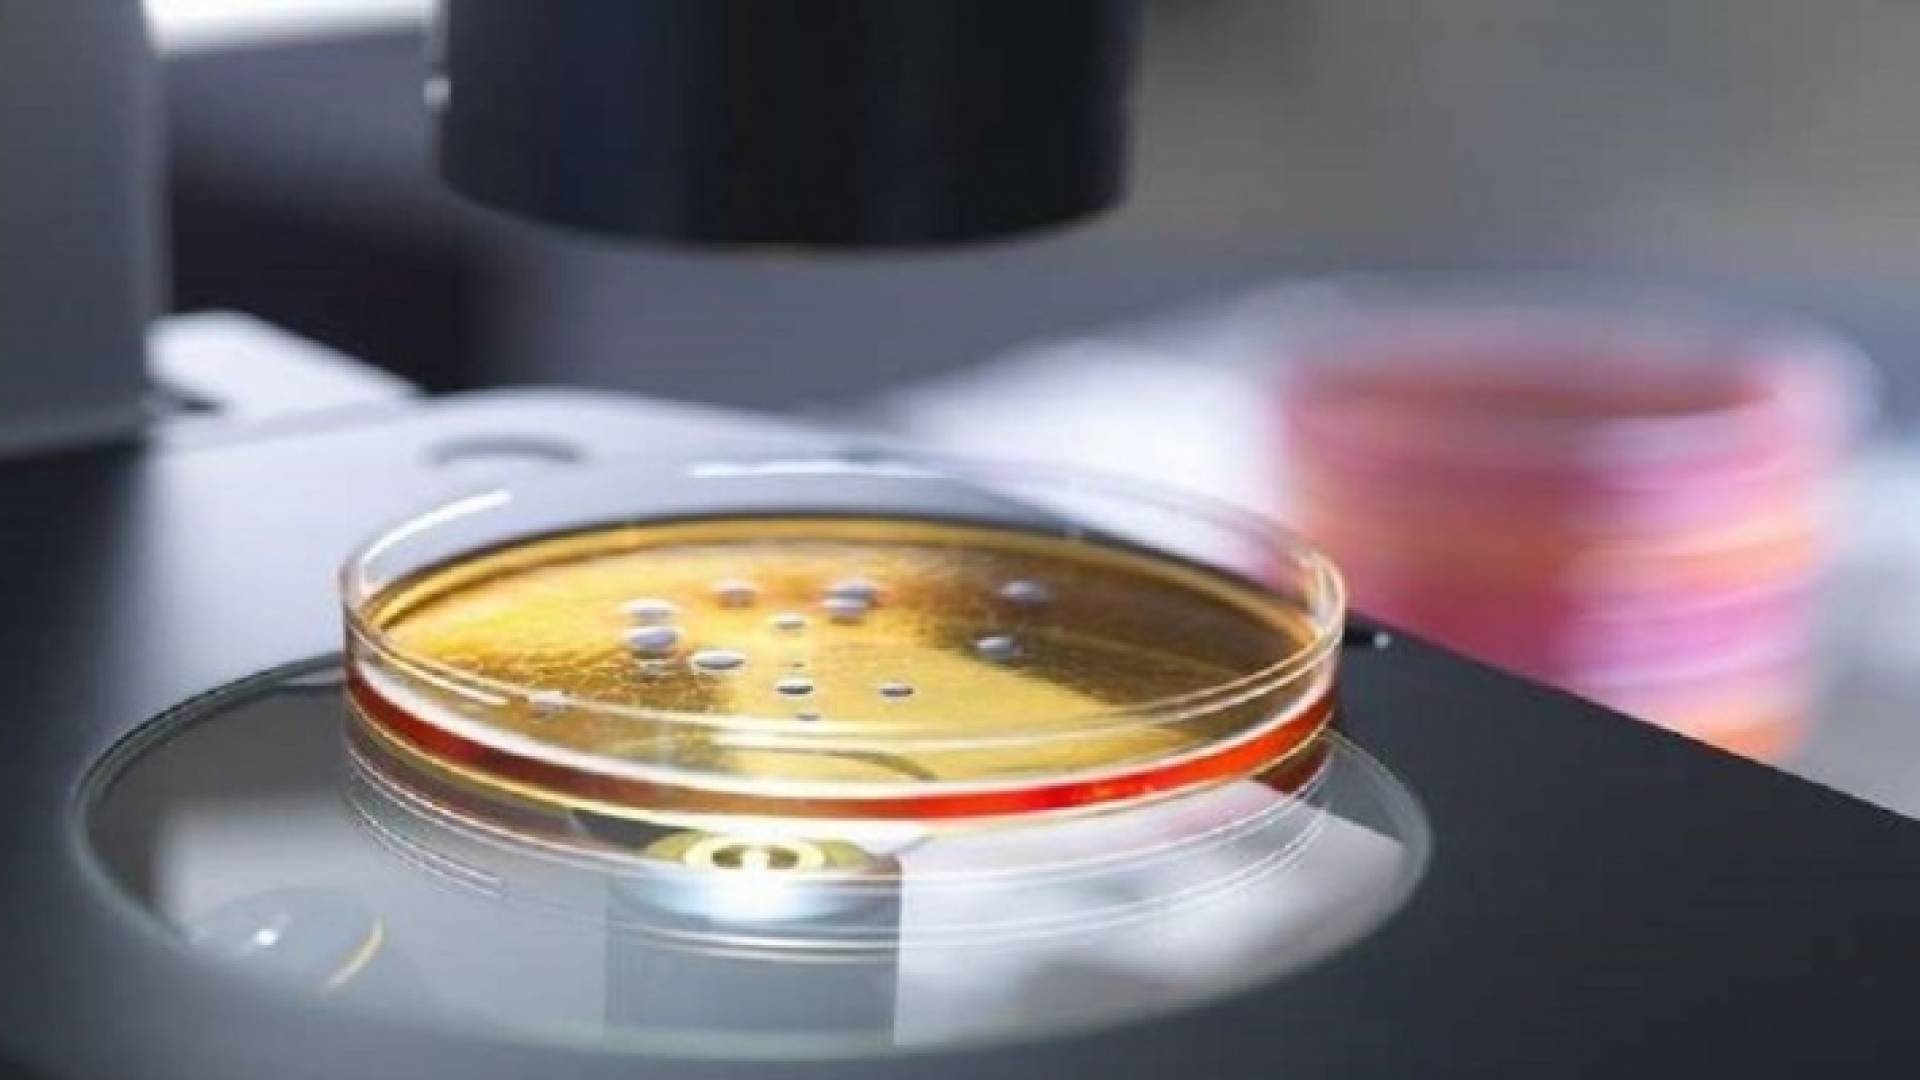
تعبيرية

تعبيرية
البكتيريا قد تصبح أكثر فتكا بالبشر من السرطان
كشفت دراسة علمية حديثة أنه خلال 30 عاما قد تصبح البكتيريا المقاومة للمضادات الحيوية أكثر فتكا بالبشر من السرطان في جميع أنحاء العالم. وتنتشر البكتيريا الخبيثة التي تحورت لتصبح غير قابلة للعلاج بالمضادات الحيوية بسرعة وأصبحت تشكل تهديدا خطيرا للصحة العامة في جميع أنحاء العالم، حسبما ذكرت صحيفة "ديلي ميل"
ويتم تغذية أعدادها المتزايدة من خلال وصفات طبية مفرطة ونفايات مصانع تصنيع الأدوية واستخدام المضادات الحيوية في الحيوانات وحتى السفر الدولي ويموت ما لا يقل عن 23 ألف شخص في الولايات المتحدة بسبب عدوى مقاومة للمضادات الحيوية كل عام كما تشير بعض التقديرات إلى أن الوفيات أكثر من ذلك بكثير
وبحلول عام 2050 تشير بعض التوقعات إلى أن مقاومة العقاقير بشكل عام ستودي بحياة 10 ملايين شخص أي أكثر من الـ 8.2 مليون شخص الذين يموتون بسبب السرطان في جميع أنحاء العالم.
وقال الدكتور "إدوارد ريان" أخصائي الأمراض المعدية في ماساتشوستس والمعد الرئيس للدراسة، إن نحو واحد من كل ثلاثة مسافرين دوليين يعود إلى الوطن وهو يحمل البكتيريا المقاومة لكن ليس بالضرورة أن يكون مصابا بها، وفقا لدراسة مستمرة للمسافرين ومقاومة مضادات الميكروبات.